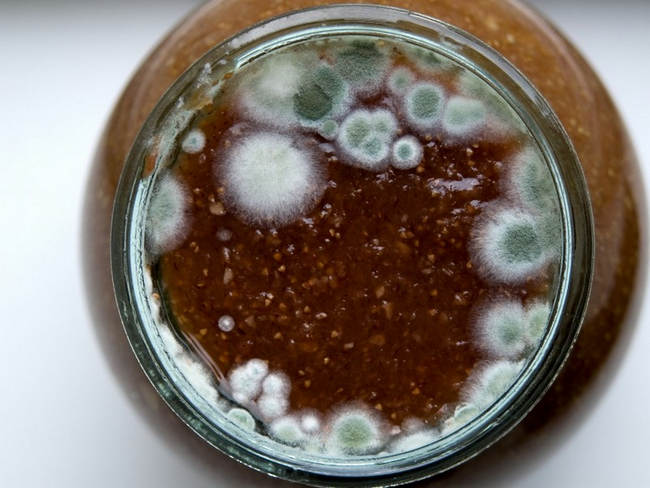

Біла, жовта або зелена пліснява на варенні — це грибок, який уражає продукти. Для того, щоб колонії швидко розмножувалися, їм потрібні волога і кисень. Тобто якщо банку з варенням закрито нещільно — будьте готові до появи цвілі. Також вона може виникнути через інші обставини: ви використовували вологі ягоди; мало поклали цукру в варення; зберігали в сирому і вологому приміщенні; недостатньо довго кип’ятили варення і воно не просочилося цукром; залишили занадто багато повітря між банкою і кришкою.
Також причиною появи цвілі може стати висока вологість повітря на кухні в момент варіння варення. Для того, щоб цього не сталося, варення краще робити в сухий і сонячний день. У банки заливати потрібно тільки гаряче, неостигле, варення. Якщо хочете додатково захистити продукт — обмотайте горлечко пергаментним папером, а тільки потім закатуйте кришками.
Цвіль і білого, і зеленого кольору шкідлива для організму, оскільки це різноманітні гриби, які містять токсини. Чи можна прибрати цвіль і їсти? Ні, грибок може «прорости» на всю банку, навіть якщо прибрати ложкою верхній білий або зелений шар. Людське око не здатне побачити, що відбувається всередині ємності, але здатне відчути — якщо є запах і присмак плісняви, то таке варення треба викидати і вживати в їжу його категорично не можна.
Якщо вживати варення з пліснявою, то це насамперед може призвести до алергічних реакцій, а потім, зокрема, до отруєння і дизентерії.
Деякі люди вважають, що вихід — в термічній обробці. Якщо ви зняли верхній шар плісняви, скуштували варення і не відчули присмаку несвіжості, то можна спробувати. Але так, щоб точно «вбити» всі небезпечні грибки. Слід додати 200–300 грамів цукру, довести до кипіння, щоб утворилася піна, яку потрібно потім зібрати й викинути. Іншу частину продукту можна їсти.
Важливий момент: намагатися врятувати варення можна, тільки якщо шар цвілі не перевищує 2 см. Якщо після того, як ви прибрали плісняву, все одно залишився запах або присмак — грибок вразив усе варення, і йому вже допомогти не можна.
Загалом, наявність цвілі свідчить про зміну складу, кислотності та інших якостей продукту. Безпеку гарантувати важко. А тому краще не вживати таке варення.